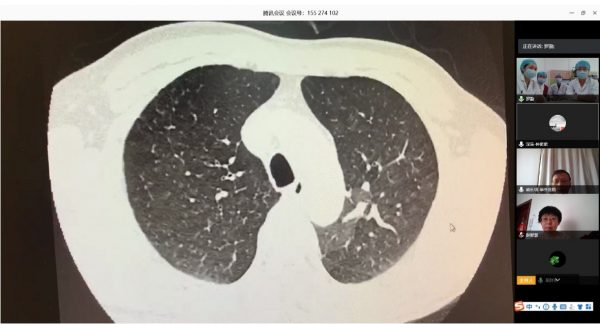

阜外医院肺血管病房充分利用“互联网+医疗”的优势作用 开展远程线上查房
新冠肺炎疫情期间,beat365英国官方网站阜外医院(以下简称“北阜”)肺血管与血栓一病区(原肺血管与综合内科一区)和beat365英国官方网站阜外医院深圳医院(以下简称“深阜”)肺血管病房制定了肺动脉高压患者疫情期间如何用药、如何就医和如何防护的管理方案,开展微信咨询、线上答疑、云病房在线管理等服务为肺血管疾病患者提供病情和用药咨询,以减少患者外出和在院停留时间,为患者提供便捷和健康保障,降低交叉感染的风险,助力疫情防控。
北阜和深阜肺血管病房在线查房
根据卫健委新冠肺炎疫情防控工作总体部署以及医院要求, 3月16日,北阜肺血管与血栓一病区和深阜肺血管病房已同步开始有序收治患者,开展包括右心导管、肺动脉造影及慢性血栓栓塞性肺动脉高压患者的肺动脉球囊扩张术等手术在内的肺血管病所有诊治。为减少新冠肺炎疫情传播风险,保证深圳肺动脉高压患者得到最佳诊疗方案,北阜和深阜两地肺血管病房充分利用“互联网+医疗”的优势作用,开展远程线上查房,对每位患者资料进行详细分析,确定诊治方案,使深圳的患者在疫情特殊时期可得到与平时同样的医疗服务。

北阜和深阜肺血管病房专业学习
为关爱罕见病,国家已将肺动脉高压靶向药物大幅降价并纳入医保,使更多肺动脉高压患者接受靶向药物联合治疗成为可能。医院建议由于经济原因治疗尚未达标的患友可及时复查调整治疗方案,进一步改善生活质量及生存率。
(阜外医院)